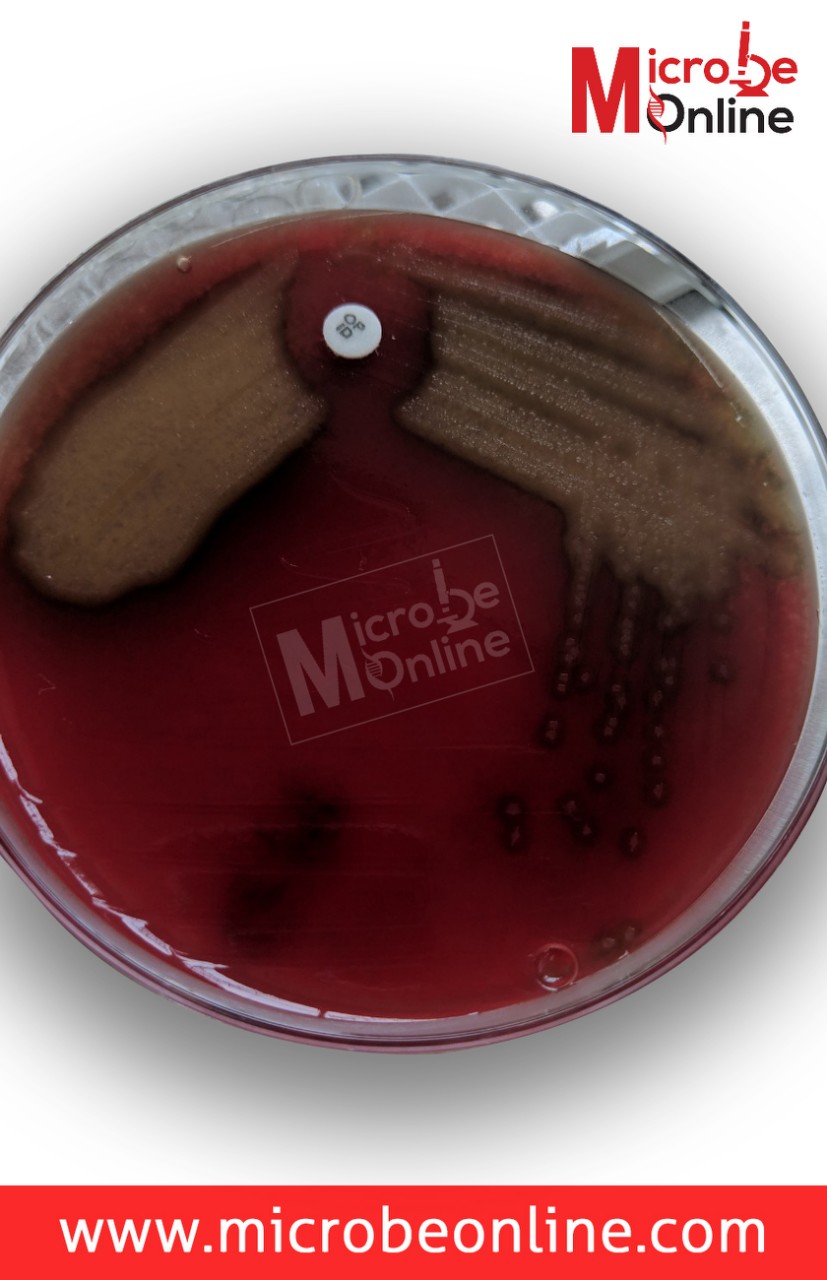
Streptococcus pneumoniae with optochin sensitivity - Optochin sensitive colonies ofS. pneumoniae

Sputum, also known as phlegm, is a thick type of mucus in a person’s lungs suffering from an infection or chronic illness affecting the lungs or airways. **The first morning expectorated sputum sample is always best for diagnosing lower respiratory tract infections.**It is essential that the specimen for culture be sputum and not saliva or nasopharyngeal secretions.
Sputum has been the primary means of determining the causes of lower respiratory tract infections such as bronchitis, bronchiolitis, and pneumonia. The symptoms suggestive of pneumonia include fever, chills, chest pain, and cough. In addition to respiratory symptoms, 10% to 30% of patients with pneumonia complain of headache, nausea, vomiting, abdominal pain, diarrhea, and myalgias.

Induced sputum, endotracheal or tracheostomy suction specimen, transtracheal aspirates are other alternatives for expectorated sputum when the patient is uncooperative, pediatric patients or has special conditions/requirements. Sputum samples can be obtained using bronchoscopy, e.g., bronchial washings, aspirates, and bronchoalveolar lavage (BAL).
Sample Collection
Expectorated Sputum
- Do not allow the patient to eat food for 1 to 2 hours before expectoration
- Ask the patient to brush teeth and then rinse mouth with saline or water just before expectoration
- Give the patient a sterile, wide-mouthed, screw-top container to collect a sputum sample
- Instruct the patient to provide a deep-coughed specimen by collecting the coughed material (sputum) into a sterile container by avoiding contamination with saliva.
- Transport the sputum sample immediately to the laboratory. Delay in transport may result in loss of viable infectious agents and recovery of pathogens.
Induced sputum
Induced sputum is used to diagnose P. jiroveciipneumonia, and LRTI caused by mycobacteria or fungal agents. If a patient cannot produce sputum, respiratory therapists may use postural drainage and thoracic percussion to stimulate the production of acceptable sputum.
- Allow the patient to breathe aerosolized droplets using an ultrasonic nebulizer containing 10% 0.085% NaCl or until a strong cough reflex is initiated.
- Collect the specimen in a sterile container.
Sputum sampled collected this way may appear watery, resembling saliva but are usually adequate for culture. The induced sputum sample should be labeled accordingly so that the laboratory accepts it without prescreening.
Lower respiratory tract samples collected via tracheal aspirate, bronchoalveolar lavage, or lung biopsy bypass the possibility of contamination with normal upper respiratory tract flora and are more likely to provide an accurate microbiological diagnosis.
Endotracheal or tracheostomy suction specimens
Patients with tracheostomies cannot produce sputum in the normal fashion, but lower respiratory tract secretions can easily be collected in a Lukens trap. The laboratory should treat tracheostomy aspirates or tracheostomy suction specimens as sputum. The clinical significance of the culture isolates should be evaluated based on clinical signs and symptoms as these patients get colonized by gram-negative bacilli or nosocomial pathogens rapidly.
Bronchoscopy specimens
Respiratory physicians can obtain bronchial washings or aspirates, bronchoalveolar lavage (BAL) samples during bronchoscopy by inserting a small amount of sterile physiologic saline into the bronchial tree and withdrawing the fluid. These specimens may get contaminated with normal flora of the upper respiratory tract. Sample collected through bronchoscopy is suitable for detecting most major respiratory tract pathogens, including Pneumocystis jiroveciicysts and fungal elements.
Sputum Processing
Direct visual examinations of Lower respiratory specimens: KOH preparation or periodic acid-Schiff-stained smears for fungal element detection, Gram staining (for bacteria and yeasts), Ziehl Neelsen staining for Mycobacterium tuberculosis (or Kinyoun carbolfuchsin stain, auramine or auramine-rhodamine) is commonly used direct examination methods for the detections of pathogen causing lower respiratory tract infections. The selection of a particular method depends on the clinical presentation as per the request of a physician.
The quality of the sputum specimen can be determined by examining Gram-stained smears. A reliable expectorated sputum sample has more than 25 leukocytes (pus cells) and fewer than 10 epithelial cells per lower power field. The culture and interpretation of an unreliable sputum sample can be misleading and should be rejected by the laboratory. If large numbers of typical organisms are seen in a good sputum sample, a preliminary assessment of the cause of pneumonia can be made.
Culture of Respiratory tract sample:
Sputum culture is performed to determine the infectious etiologies of pneumonia or pulmonary tuberculosis. The most frequent bacterial cause of community-acquired pneumonia is Streptococcus pneumoniae, whereas *S. aureus,*and gram-negative rods, such as K. pneumoniae and P. aeruginosa, are the common causes of hospital-acquired pneumonia.
If a few colonies of Gram-negative rods are isolated from the sputum or throat swab of a hospitalized patient, further identification and anti-microbial susceptibility testing are of no clinical relevance, since neither procedure will have any effect on the treatment of the patient.
Routinely used culture media to isolate common etiologic agents of lower respiratory tract infections are; 5% sheep blood agar, MacConkey agar (for isolation and differentiation of gram-negative bacilli), and chocolate agar****(for Haemophilus and Neisseriaspp). For suspected cases of legionnaires’ disease, buffered charcoal-yeast extract agar (BCYE), and Lowenstein Jensen medium is used for pulmonary tuberculosis.
- Blood culturesaccompanying sputum specimens may occasionally be helpful, particularly in high-risk community-acquired pneumonia patients.
- The laboratory should be contacted for specific instructions before collecting specimens for fastidious pathogens such as Bordetella pertussis.
- The range of pathogens causing exacerbations of lung disease in cystic fibrosis patients has expanded, and specimens for mycobacterial and fungal cultures should be collected in some patients.
- A broad diagnostic approach based on invasively obtained specimens is suggested in the immunocompromised host.
- Most negative rapid antigen test results should be confirmed by another method.NAATs have largely replaced rapid antigen tests and cultures for respiratory virus detection.
- Calcium alginate swabs are not acceptable for nucleic acid amplification testing.
- Bronchoscopy with washings is the optimal diagnostic specimen in pediatrics.
List of Bacteria causing Respiratory Tract Infection
- Definitive pathogens
Bordetella pertussis Chlamydia trachomatis Chlamydophila pneumonia Mycoplasma pneumoniae Mycobacterium tuberculosis Corynebacterium diphtheriae(toxin-producing) Legionella spp
B: Possible pathogens
- Streptococcus pneumoniae
- Staphylococcus aureus
- Neisseria meningitidis
- Haemophilus influenzae
- Haemophilus parainfluenzae
- Pseudomonas spp
- Enterobacteriaceae
- Moraxella catarrhalis
List of fungal pathogens causing lower respiratory tract infections
- Pneumocystis jiroveci(Pneumocystis carinii)
- Nocardia spp
- Histoplasma capsulatum
- Coccidioides immitis
- *Cryptococcus neoformans (*may also be recovered from patients without disease)
- Blastomyces dermatitidis
References
- Shen F, Sergi C. Sputum Analysis. [Updated 2023 Feb 20]. In: StatPearls [Internet]. Treasure Island (FL): StatPearls Publishing; 2023 Jan-. Available from: https://www.ncbi.nlm.nih.gov/books/NBK563195/
- Datta, S., Shah, L., Gilman, R. H., & Evans, C. A. (2017). Comparison of sputum collection methods for tuberculosis diagnosis: a systematic review and pairwise and network meta-analysis. The Lancet. Global health, 5(8), e760–e771. https://doi.org/10.1016/S2214-109X(17)30201-2
- Joyce S. M. (1986). Sputum analysis and culture. Annals of emergency medicine, 15(3), 325–328. https://doi.org/10.1016/s0196-0644(86)80576-5
- Nascimento, C. P. D., Hadad, D. J., Castellani, L. G. S., Almeida Júnior, P. S., Dietze, R., & Palaci, M. (2018). Sputum sample collected over a period of 5 h: A reliable procedure for early bactericidal activity studies. Diagnostic microbiology and infectious disease, 92(1), 25–30. https://doi.org/10.1016/j.diagmicrobio.2018.04.013